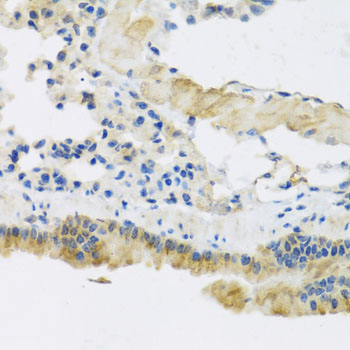
Immunohistochemistry - CLIP1 Polyclonal Antibody

-
Product Name
CLIP1 Polyclonal Antibody
- Documents
-
Description
Polyclonal antibody to CLIP1
-
Tested applications
WB, IHC
-
Species reactivity
Human, Mouse, Rat
-
Alternative names
CLIP1 antibody; CLIP antibody; CLIP-170 antibody; CLIP170 antibody; CYLN1 antibody; RSN antibody; CAP-Gly domain-containing linker protein 1 antibody
-
Isotype
Rabbit IgG
-
Preparation
Antigen: Recombinant fusion protein containing a sequence corresponding to amino acids 1228-1427 of human CLIP1 (NP_002947.1).
-
Clonality
Polyclonal
-
Formulation
PBS with 0.02% sodium azide, 50% glycerol, pH7.3.
-
Storage instructions
Store at -20℃. Avoid freeze / thaw cycles.
-
Applications
WB 1:500 - 1:2000
IHC 1:50 - 1:200 -
Validations

Western blot - CLIP1 Polyclonal Antibody
Western blot analysis of extracts of various cell lines, using CLIP1 antibody at 1:1000 dilution.Secondary antibody: HRP Goat Anti-Rabbit IgG (H+L) at 1:10000 dilution.Lysates/proteins: 25ug per lane.Blocking buffer: 3% nonfat dry milk in TBST.Detection: ECL Basic Kit .Exposure time: 90s.
Immunohistochemistry - CLIP1 Polyclonal Antibody
Immunohistochemistry of paraffin-embedded mouse lung using CLIP1 antibody at dilution of 1:100 (40x lens).

Immunohistochemistry - CLIP1 Polyclonal Antibody
Immunohistochemistry of paraffin-embedded rat heart using CLIP1 antibody at dilution of 1:100 (40x lens).

Immunohistochemistry - CLIP1 Polyclonal Antibody
Immunohistochemistry of paraffin-embedded human stomach using CLIP1 antibody at dilution of 1:100 (40x lens).
-
Background
Binds to the plus end of microtubules and regulates the dynamics of the microtubule cytoskeleton. Promotes microtubule growth and microtubule bundling. Links cytoplasmic vesicles to microtubules and thereby plays an important role in intracellular vesicle trafficking. Plays a role macropinocytosis and endosome trafficking.
Related Products / Services
Please note: All products are "FOR RESEARCH USE ONLY AND ARE NOT INTENDED FOR DIAGNOSTIC OR THERAPEUTIC USE"
